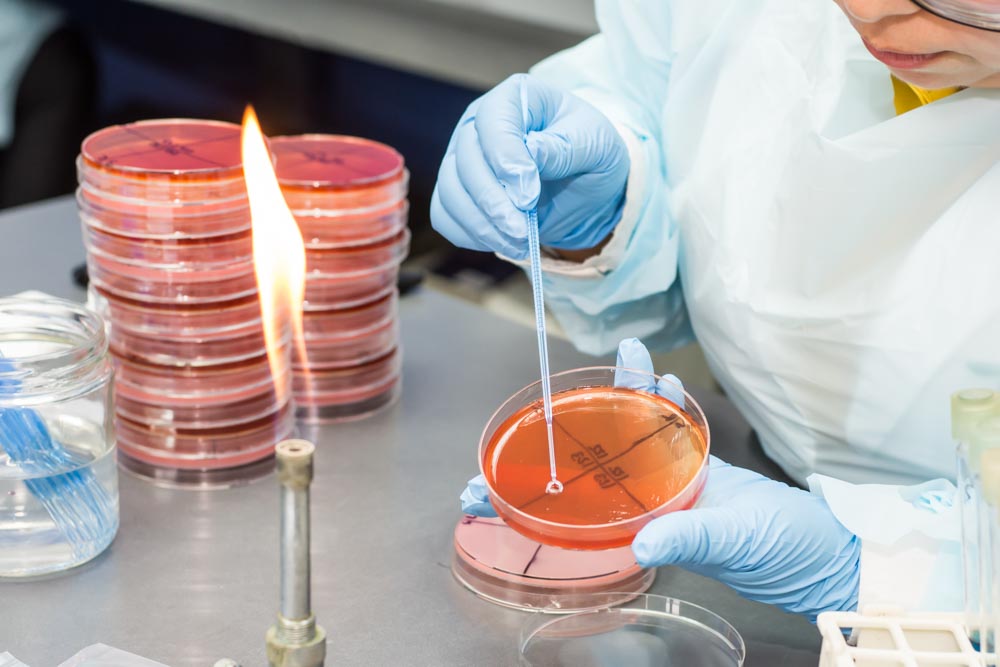
Una herramienta predictiva del rendimiento de los suelos para el cultivo del olivo

La empresa AGQ Labs desarrolla un proyecto de I+D+i, en colaboración con la Universidad de Sevilla y con financiación de CTA, para conseguir una nueva metodología que aplica Inteligencia Artificial para interpretar datos complejos procedentes de análisis metagenómicos, bioquímicos y fisicoquímicos del suelo del olivar
La empresa andaluza AGQ Labs ha desarrollado un proyecto de I+D+i, en colaboración con la Universidad de Sevilla (US) y la empresa madrileña Helix BioS y con financiación de CTA (Corporación Tecnológica de Andalucía), para conseguir una nueva herramienta predictiva del rendimiento de los suelos para el cultivo del olivo. La nueva metodología aplica Inteligencia Artificial (IA), en concreto Machine Learning, para interpretar datos complejos procedentes de análisis metagenómicos, bioquímicos y fisicoquímicos del suelo.
La herramienta, que ofrecerá una ventaja competitiva clara a los agricultores, permitirá reducir el impacto ambiental del cultivo del olivo, disminuir el consumo de agua y abonos nitrogenados, mejorar la resiliencia de los cultivos frente a los desafíos ambientales y fomentar la biodiversidad y conservación del suelo. En una segunda fase, se podrá extender a todo tipo de cultivos.
El presidente ejecutivo de AGQ Labs, Estanislao Martínez, sostiene que “la labor de la CTA en la promoción de proyectos colaborativos entre el sector público y privado es fundamental para impulsar la adopción de nuevas tecnologías en sectores estratégicos como la agricultura. Gracias a su apoyo, se desarrollan soluciones innovadoras que incrementan la eficiencia y sostenibilidad de los cultivos. El programa de incentivos a la I+D+i de CTA ha demostrado ser un catalizador clave para reducir los riesgos asociados a la inversión en el desarrollo de nuevas herramientas biotecnológicas, facilitando el acceso a financiación y ampliando las posibilidades de éxito de los proyectos”.
Por su parte, la responsable técnica del sector Agroalimentario en CTA, Nathalie Chavrier, apunta que “conocer mejor la salud de los suelos es un hito relevante para contribuir a la sostenibilidad de los sistemas agrícolas”. En su opinión, el proyecto de AGQ Labs “permitirá obtener modelos predictivos de comportamientos de los suelos y de la producción agrícola, más completos, y constituir el núcleo de una herramienta de ayuda a la toma de decisión para los agricultores”.
Machine Learning para predecir el rendimiento y salud del suelo
El proyecto SoilForecast de AGQ Labs ha tenido como objetivo técnico principal investigar una nueva metodología, basada en la integración de datos complejos procedentes de análisis metagenómicos, bioquímicos y fisicoquímicos del suelo agronómico mediante técnicas de “Machine Learning” que permita establecer un primer modelo matemático predictivo de la funcionalidad, fertilidad, biodiversidad y salud biológica de los suelos del cultivo del olivo. De esta forma, la herramienta permitirá predecir las prácticas más adecuadas para el rendimiento de los suelos agronómicos y la calidad y/o diversidad biológica.
José Antonio Carrasco, doctor en Biología Molecular y Project Manager de I+D en AGQ Labs, señala que el proyecto refuerza la colaboración de la empresa con la Universidad pública para la transferencia de tecnología, ya que se desarrolla en colaboración con el grupo de investigación BIO 181 Fitomicrobiomas como herramientas biotecnológicas, del Departamento de Microbiología y Parasitología de la Universidad de Sevilla.
Carrasco explica que el microbioma del suelo, formado por los microorganismos que habitan en él, tiene un papel fundamental en el desarrollo y la salud de un cultivo, pudiendo influir en su resistencia a la sequía, en la disponibilidad de nutrientes como el nitrógeno o el fosforo, o en la resistencia a enfermedades, entre otros factores. Por tanto, el microbioma puede afectar a la resistencia del olivo al cambio climático, a su productividad y a la calidad de las aceitunas. Una vez finalizado el proyecto, esta tecnología se extenderá a cualquier tipo de cultivo.
Por ello, la herramienta que desarrolla AGQ Labs permitirá analizar las características de los suelos para el cultivo de olivo y predecir las necesidades y comportamiento en función de ellas, pero también permitirá en el futuro tomar decisiones a los agricultores respecto al tratamiento del suelo. El Dr. Carrasco afirma que “las nuevas generaciones de agricultores tienen cada vez más interés en las nuevas tecnologías, necesitan expertos y herramientas de asesoramiento que les ayuden en la interpretación de datos y en la toma de decisiones para el manejo de sus cultivos”.
Con el desarrollo de esta herramienta, AGQ Labs incorpora nuevas tecnologías a su portfolio y podrá ofrecer un servicio innovador que complementa perfectamente el seguimiento y control nutricional que, basado en análisis físico-químicos y valuación de la respuesta de la planta a la fertirrigación aplicada, un servicio con el que AGQ Labs viene asesorando 1,5 millones de hectáreas a nivel internacional.
La pérdida de suelo cultivable es uno de los grandes retos para la producción agrícola mundial. Según la FAO, el 33% del suelo mundial ya está degradado, existiendo el riesgo de alcanzar el 90% para 2050. Adicionalmente, la erosión del suelo puede reducir hasta un 50% la producción agrícola. De ahí la importancia de herramientas como ésta, ya el papel del microbioma en la salud del suelo y la producción agrícola sostenible es cada vez más claro.